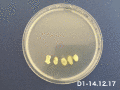

SLIME MOLDS
Color: Yellow
Size: Depending on growing
Species: Single-celled organism(belonging to the kingdom of the amoeba)
Ability: Joining together with other cells to form a mass super-cell connective net to maximise its resources
Habitat: Dark, damp and warm place(naturally foraging in woodlands)
Favorite food: Porridge oats(naturally eating rotting vegetation)
Character: Mapping its territory, knowing itself, and move with seeming intention
Intelligence support: The continuous, synchronous oscillation within the cell (A vein-like structure carrying cellular material, nutrients and chemical information through the cell, streaming first in one direction and then back in another. The continuous, synchronous oscillation within the cell.)
Motto: No Brains, No Feet, No Problem
"Achievement": Building Tokyo rail system in one day; Providing references for Artificial Intelligence.
EXPERIMENT
First try - Agar medium and paper on December
December 13th
Extracted the slime molds in three different dishes on the agar medium. One is the tube with oats randomly on the wall of the tube. The second one is the dish with a piece of cutting paper and the oats on the head. The last one is the dish with 5 oats in a line.
December 14th - December 20th Observation GIF
Summary:
1. The trails of the slime molds growing became white from yellow, also they grow so fast and I didn't document the processing of the changes. According to the observation, they moved as a group and was always in connection. For observing much more movement, I would try to change the times of observation and documents.
2.Slime molds didn't grow out of my expectation in a dispersed way. They grew towards different directions in different time (from right side to left, and back to right ), rather than spreading to all directions at the same time.
3.I tried use the tube with agar full of inside to grow slime molds. Unfortunately, slime molds were only alive around one piece of oat, and becoming sick 7days later. The difference from the living of slime molds is air.
Second try - Agar medium with mushroom 10th January-17th January
According to reference who fed the slime molds as pet, the slime molds live under the woodlands where is dark and damp and enjoy the mushroom. I tried to use mushroom to feed it and put it in the package to store. However there was no reaction from slime molds, even the mushroom was rotting. And the temperature was almost kept during 21℃-26℃.
Third try - Only agar medium and oats 17th January-24th January
There were lots of other tiny molds grew during this time. And they also connected into a almost transparent 3D net. However the environment still didn't wake the slime molds up, because of the uncontrolled temperature, humidity and polluted oats.
IDEA-PRIMARY
According to the situations they grow, it can be imagined as different hair stylesand so on. Also, it can be imagined people will be in different emotions (happiness, sadness ,confusing...)according to the all kinds of hair styles. Assumption 1: As the intelligence of the slime molds, if they grow on the real hair, they may shape the different hair style according to the situation(the health level of the scalp) of the human head. Assumption 2: The slime molds always explore as navigators, they are also designers, to create different artistic form can be learned as a style to human.
CONCLUSION-1
A). Some environmental elements influence the growth of slime molds: temperature, humidity, light and food. So using these elements will create the favorable or unfavorable state to control the growth trails of slime molds. And also slime molds have "memory", which can be used as one kind of controlling method.
B). A slime mold is a thing of beauty. In spring and summer period, slime molds grow vigorously, and the single slime mold also grow into a strong shape. Surely, growing in the group way is the method of living to them.
EXPERIMENT-GROWTH OF SLIME MOLDS
Fourth try - on the paper from 1st February to 5th February
From last experiments and studies, the topic 'how can slime molds alive' is more important for me. With the living sample from Miga, there was another try to grow slime molds. Luckily, the slime molds alive on the wet paper. Controlling the temperature in a relatively stable situation(20℃-25℃), keeping the paper wet, using the clean oats, the slime molds grew in a slow way.
Fifth try - on the paper from 13th February to 20th February
The aim of this experiment was to text the necessity of water and the different status of oats. So I made 5 different samples: a) half wet paper with slime molds and half dry paper with clean oats; b) the whole wet paper with slime molds and clean oats lying at 2 sides; c) small amount of boiled oats at centre with slime molds; d) one side with boiled oats and slime molds; e) one side with boild oats and another side with slime molds. Only controlled the temperature in a relatively stable situation (20℃-25℃). Finally, there was no slime molds alive in these living environment. Although the boiled oats can provide water but slime molds seem not like boiled food.
CONCLUSION
It is interesting to observe a kind of single-celled organism as a pet to care about their habits. That's not only the reason that they can find the food in a wise way, also they are sensitive with the living environment. The tiny organism also shows the power of life, struggle in the world. Most of their life, they spread fast into anywhere with foods. But they will disappear when they are cold, hungry, thirsty like human. Sometimes they are dry and 'quite' to wait 'Spring', the suitable situation for them. If anyone would like to grow them at home, you need to be sure that you can control the temperature in a stable way, keep the room wet, and provide clean food to treat them as pet. And it will be a better time to grow them in warm season.